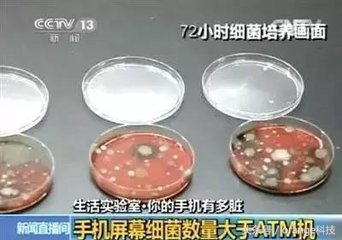
经常清洁手机屏幕会有什么不好吗,手机屏幕太脏用什么清洗

随着科技的发展,手机渐渐普及,通讯和互联网的高速发展,手机已经不仅仅只是一个通讯工具那么简单。它连接着我们身边的以很多东西,衣食住行基本可以通过手机搞定。手机已经成了我们生活中必不可少的一部分,我们无时无刻机不离手。然而作为与我们接触频率最高的东西,你知道它有多脏么?
为了验证手机有多脏,湖南师大的胡胜标博士也做了一个实验,他抽查了6个样板手机、4个马桶。最终得出,6个样板手机中每部手机平均有2500个细菌数量/平方厘米;而马桶细菌数量最多的仅有440个/平方厘米。手机不仅比马桶冲水手柄脏,甚至比马桶坐垫还要脏。


手机上的细菌都是来自哪里呢?打电话时,脸上的油脂、皮屑、汗液会粘到手机屏幕上;用脏的双手在触屏上来回滑动,这些都为病菌的大量滋生提供了有利条件。而且,手机作为一个电子产品,通常很少人会对它做相应的清洗的,这也使得细菌在手机上的进一步富集。

在日常生活中,我们会遇到这样的问题,比如用接触过手机的手揉眼睛、擦鼻子,或是不洗手直接去拿食物吃,就可能将手机上的病菌带入体内,引起各种疾病,比如腹泻、感冒、眼部感染等,这并不是危言耸听。所以,我们应该保持良好的卫生习惯,经常对手机进行清洗,消毒。
建议每隔三个月到半年更换一次贴膜。如果在如厕时用过手机或将手机借给过别人使用,建议立刻消毒。
怎么给手机消毒呢?
消毒时,应先用洗洁精去除手机表面油脂;再用棉球蘸取医用酒精(浓度为75%),挤出多余的酒精,使棉球刚好湿润又不会滴下酒精来,以防酒精流入手机内部,造成手机故障等;轻轻用其擦拭手机表面两遍,除了手机正反两面外,不要忽略了听筒、话筒、耳机孔、充电接线孔以及手机的边缝接合处等。此外,直接用手机专用清洁喷雾,也是一个简单易行的办法。另外还可以用牙膏和眼镜清洗液来对手机进行清洁。
欢迎大家评论,点赞,转发,收藏,喜欢的话还可以关注一下头条号,更多科技,数码精彩内容,尽在orange科技